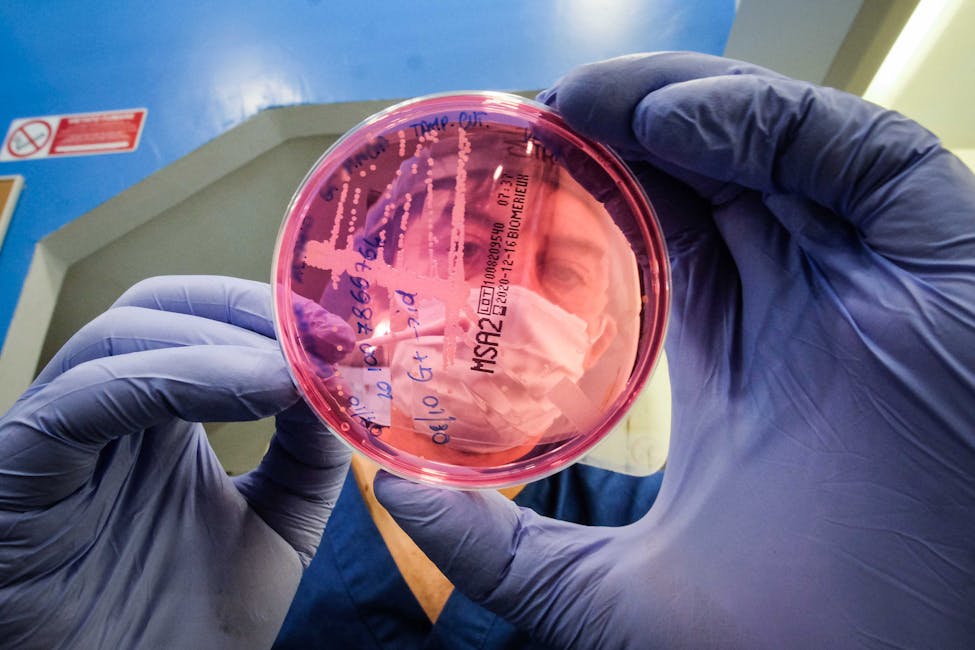
Analisi

Arsene, "Didi" per gli amici, si occupa del decoro, della disinfezione e dell'ordine di tutti gli ambienti del Vet Hospital sin dal 2017.
Didi è una parte fondamentale del team perché permette ai medici di svolgere l'attività clinica in accordo ai migliori standard di disinfezione e prevenzione delle contaminazioni, aspetto fondamentale nella cura dei nostri pazienti.









